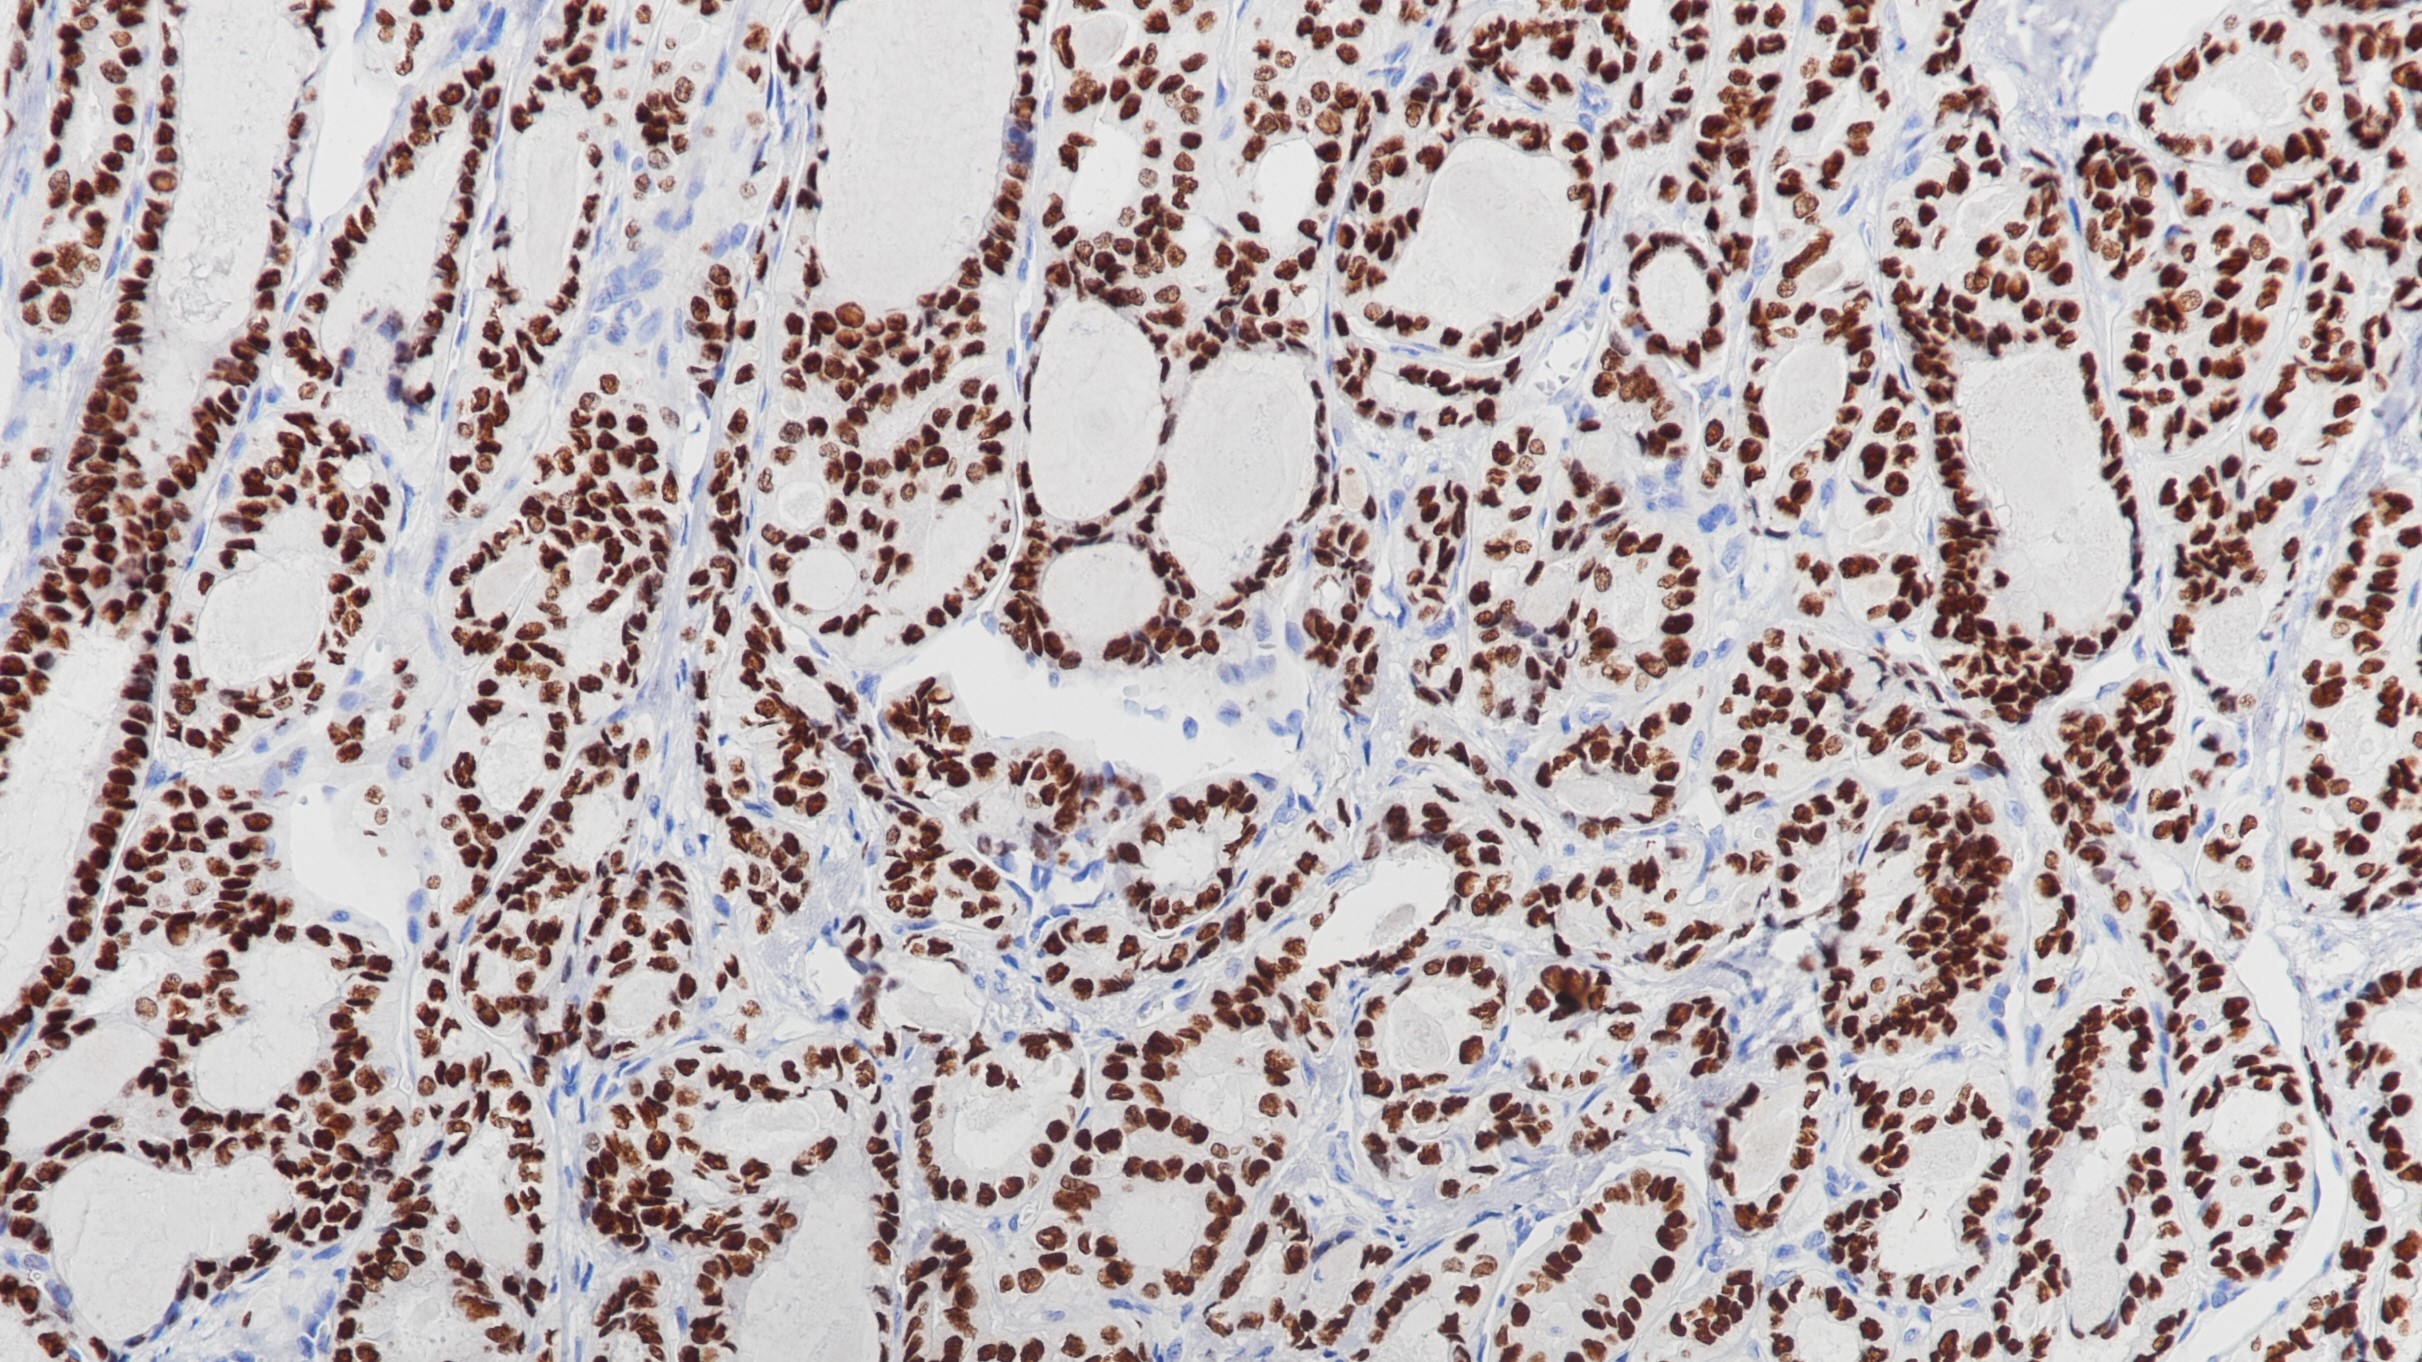
甲状腺TTF-1(BP6079)染色

1. Loreto C D , Puglisi F , Lauro V D , et al. TTF-1 protein expression in pleural malignant mesotheliomas and adenocarcinomas of the lung[J]. Cancer Letters, 1998, 124(1):0-78.
2. Wu M ,Szporn A H , Zhang D , et al. Cytology applications of p63 and TTF-1 immunostaining in differential diagnosis of lung cancers[J]. Diagnostic Cytopathology, 2005, 33(4):223-227.
3.中华医学会.《临床技术操作规范·病理学分册》.人民军医出版社,2004.